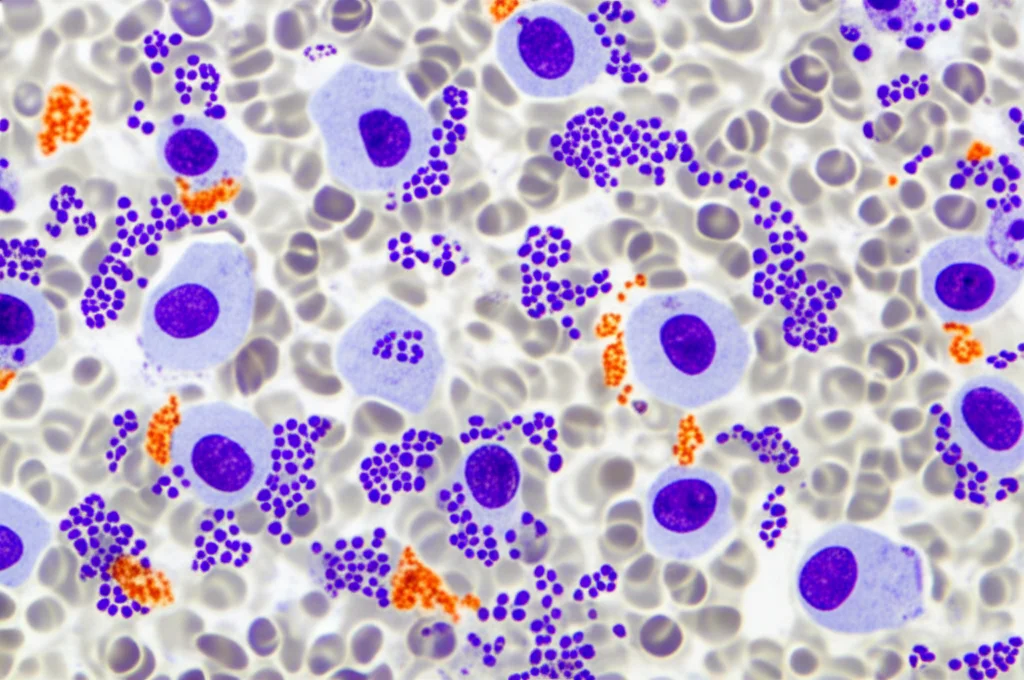
Immagine macro ad alta definizione di cellule del midollo osseo al microscopio elettronico, con alcune cellule leucemiche residue evidenziate, illuminazione controllata ad alto contrasto, lente macro 105mm, focus estremamente preciso sui dettagli cellulari.

LMA e Trapianto: La Combo MRD che Prevede il Futuro Meglio di una Sfera di Cristallo!
Ciao a tutti! Oggi voglio parlarvi di qualcosa che mi appassiona tantissimo e che sta cambiando le carte in tavola nella lotta contro la Leucemia Mieloide Acuta (LMA), una bestiaccia ematologica piuttosto aggressiva. Parliamo di trapianto allogenico di cellule staminali ematopoietiche (allo-HSCT), spesso l’unica vera speranza di cura per molti pazienti. Ma, diciamocelo, la strada è in salita e il rischio di ricaduta dopo il trapianto è un fantasma che aleggia sempre. Come possiamo anticipare questo rischio e intervenire prima che sia troppo tardi? La risposta, o almeno una parte importante di essa, sta nel monitoraggio della Malattia Minima Residua (MRD).
Cos’è la Malattia Minima Residua (MRD)?
Immaginate la MRD come le ultime cellule leucemiche “nascoste” che sfuggono alla chemioterapia e al trapianto, pronte a riorganizzarsi e a causare una ricaduta. Trovarle quando sono ancora pochissime è cruciale. Per farlo, abbiamo diverse armi nel nostro arsenale:
- Citometria a Flusso Multiparametrica (MFC): Una tecnica super diffusa, applicabile a quasi tutti i pazienti, che “fotografa” le cellule e cerca quelle con caratteristiche anomale tipiche della leucemia. Ha una buona sensibilità, ma non è perfetta e a volte interpretare i risultati è un’arte.
- PCR per anomalie genetiche specifiche: Molto sensibile, va a cercare specifiche mutazioni o geni (come *NPM1*, *RUNX1::RUNX1T1*) ma, ahimè, funziona solo se il paziente ha quel particolare “bersaglio” molecolare, cosa che non accade in almeno metà dei casi.
- Espressione del gene WT1 (via PCR): Quando le altre tecniche non sono applicabili, le linee guida suggeriscono di guardare il gene WT1. È sovraespresso in tantissimi pazienti LMA ed è un buon indicatore di prognosi infausta. Sta diventando un marcatore MRD quasi universale.
- Next-Generation Sequencing (NGS): La nuova frontiera. L’NGS è potentissimo perché può analizzare tantissimi geni contemporaneamente, rendendolo potenzialmente utile per quasi tutti. Però, costa di più, non è ancora standardizzato ovunque e richiede competenze bioinformatiche specifiche.
Insomma, ogni metodo ha i suoi pro e i suoi contro. Ma la vera domanda che ci siamo posti nel nostro studio è: qual è il momento migliore per cercare la MRD e quale metodo, o combinazione di metodi, ci dà le informazioni più affidabili sulla prognosi?
Il Tempismo è Tutto? Quando Monitorare la MRD
Abbiamo seguito 47 pazienti con LMA sottoposti a trapianto allogenico, monitorando la MRD con MFC e WT1 un mese prima del trapianto [HSCT(-1m)] e un mese dopo [HSCT(+1m)]. Con l’NGS, siamo andati oltre, controllando anche a 3 e 6 mesi dopo il trapianto [HSCT(+3m) e HSCT(+6m)].
I risultati sono stati illuminanti! Abbiamo visto che, sia per la MFC che per l’espressione di WT1, lo status della MRD prima del trapianto [HSCT(-1m)] era un indicatore molto più potente nel predire la progressione della malattia rispetto al controllo fatto un mese dopo [HSCT(+1m)]. Sembra quasi che “fotografare” la situazione subito prima della grande battaglia (il trapianto) ci dia le informazioni più cruciali.
Per l’NGS, la storia è un po’ diversa. I controlli a 1 mese prima e 1 mese dopo il trapianto non sembravano fare una grande differenza statistica sulla sopravvivenza. Ma quando abbiamo guardato i dati a 3 e soprattutto a 6 mesi dopo il trapianto [HSCT(+3m) e HSCT(+6m)], le cose sono cambiate. La positività all’NGS in questi momenti era significativamente associata a un rischio maggiore di ricaduta e, a 6 mesi, anche a una peggiore sopravvivenza globale (OS). Quindi, per l’NGS, sembra che dare tempo al sistema immunitario del donatore di “fare pulizia” e poi controllare più tardi sia la strategia migliore per scovare quei cloni leucemici più ostinati.
L’Unione Fa la Forza: La Combo Vincente è Pre-Trapianto
Qui arriva la vera chicca del nostro lavoro. Abbiamo notato che ogni singolo metodo, preso da solo, aveva delle limitazioni. A volte la MFC era negativa ma l’NGS positivo, altre volte il contrario. Qualche paziente con MRD negativa a tutti i test post-trapianto purtroppo ricadeva comunque. Questo ci ha fatto pensare: e se li usassimo insieme?
Abbiamo analizzato i pazienti per cui avevamo i dati di tutti e tre i metodi (MFC, WT1, NGS) nello stesso momento, in particolare un mese prima del trapianto [HSCT(-1m)]. I risultati sono stati sbalorditivi. La combinazione dei tre metodi prima del trapianto ha mostrato una capacità predittiva eccezionale. Utilizzando un’analisi statistica (curva ROC), abbiamo visto che questa combinazione era superiore a qualsiasi combinazione di due metodi o a un metodo singolo nel predire la progressione della malattia.
Abbiamo definito i pazienti come “MRD+” se erano positivi ad almeno due dei tre test prima del trapianto, e “MRD-” se negativi ad almeno due test. Ebbene, i pazienti MRD+ avevano una prognosi significativamente peggiore, sia in termini di sopravvivenza libera da ricaduta (RFS) che di sopravvivenza globale (OS), rispetto ai pazienti MRD-. La sensibilità di questa strategia combinata nell’identificare i pazienti che avrebbero avuto una progressione di malattia è stata del 100%! E la specificità (cioè la capacità di identificare correttamente chi non avrebbe avuto progressione) è stata del 95%. Praticamente perfetto!

Questo suggerisce fortemente che eseguire un monitoraggio MRD combinato con MFC, WT1 e NGS prima di procedere con il trapianto allogenico potrebbe darci un quadro incredibilmente accurato del rischio individuale del paziente, permettendoci magari di personalizzare ulteriormente le strategie terapeutiche.
Non Solo MRD: Altri Fattori Contano
Ovviamente, la MRD non è l’unico fattore in gioco. Abbiamo anche analizzato altre variabili cliniche e molecolari. Ad esempio, abbiamo visto che una maggiore “quantità” di mutazioni rilevate dall’NGS prima del trapianto (in termini di VAF – Variant Allele Frequency – e numero di siti genici mutati) era associata a una prognosi peggiore. Lo stesso valeva per la persistenza di un carico mutazionale elevato a 3 e 6 mesi dopo il trapianto. Anche la citogenetica al momento della diagnosi (favorevole, intermedia o avversa) ha confermato il suo ruolo prognostico.
Cosa Portiamo a Casa?
Il succo del discorso? Il monitoraggio della MRD è fondamentale nella LMA post-trapianto. Il nostro studio suggerisce che:
- Per MFC e WT1, il momento migliore per “guardare” è prima del trapianto [HSCT(-1m)].
- Per l’NGS, i controlli più tardivi, specialmente a 6 mesi dopo il trapianto [HSCT(+6m)], sembrano dare le informazioni prognostiche più forti.
- La vera potenza sta nella combinazione! Usare MFC, WT1 e NGS insieme prima del trapianto offre una capacità predittiva straordinaria per la ricaduta e la sopravvivenza.
Certo, il nostro studio ha coinvolto un numero relativamente piccolo di pazienti, quindi serviranno conferme su coorti più ampie. Ma crediamo che questi risultati siano un passo importante per ottimizzare la gestione della MRD nei pazienti con LMA che affrontano il trapianto, aiutandoci a stratificare meglio il rischio e, speriamo, a migliorare i loro esiti a lungo termine. È un campo in continua evoluzione, ed è entusiasmante farne parte!
Fonte: Springer
